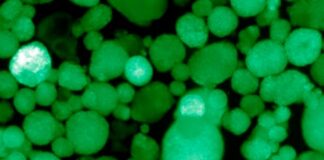
Crean las primeras células humanas trasplantables que producen insulina para tratar diabetes tipo 1

Etiqueta: Diabetes
Lo que el tamaño de tu cuello puede revelar sobre tu...
Ciudad de México, 2 Nov-25 (Agencia/VRed).- Solemos notar que estamos engordando cuando nos crece el estómago o la ropa nos aprieta.
Pero hay una zona...
En 2021 murieron un millón 117 mil 167 personas en México;...
Ciudad de México., 27 Jul-22 (Agencia).- En México se reportaron las defunciones de 1 millón 117 mil 167 personas durante 2021, así lo demuestra el Instituto Nacional de Estadística...
La OMS prioriza el acceso a los tratamientos contra la diabetes...
EUA., 11 Oct-21 (VRed).- La OMS ha publicado hoy las nuevas ediciones de su Lista Modelo de Medicamentos Esenciales y de su Lista Modelo...
Estas son algunas señales sutiles de que podrías tener diabetes
Ciudad de México., 4 Oct-21 (Agencia).- La diabetes tiene muchos signos tempranos, pero son lo suficientemente sutiles como para que no te des cuenta....
Crean las primeras células humanas trasplantables que producen insulina para tratar...
EUA, 22 Ago-20 (Agencia).- Los científicos del Instituto Salk, en Estados Unidos, han logrado un gran avance en la búsqueda de un tratamiento seguro...